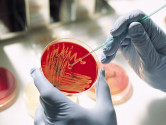

статьи о здоровье
-
Многие инфекции зачастую очень сложно определить или даже заподозрить на первых этапах развития, поскольку длительное время они протекают бессимптомно...
-
не только легкие страдают от COVID-19. Данный тип коронавируса плохо влияет на работу многих органов и систем.
-
Пищевое отравление – это острое состояние, для которого чаще всего характерно наличие расстройства пищеварения. Пищевое отравление провоцируют патоген...
-
Наличие условно-патогенных микроорганизмов – уреаплазмы, не всегда означает развитие заболевания. Очень часто их выявляют и в абсолютно здоровых людей...
-
Ежегодно в Украине несколько десятков людей отравляются грибами. Происходит это из-за нежелания употреблять в пищу сугубо грибы промышленного произво...
-
Вероятность развития гепатита А связано с отсутствием соблюдений санитарных норм, личной гигиены и плохим очищение воды. Гепатит А не является таким о...
-
Именно сейчас нужно помнить об опасности заражения такой страшной инфекционной болезнью, как столбняк.
-
Коронавирус стал огромным испытанием для людей всего мира. Ежедневно инфицированию поддаются более тысячу людей. При этом кто-то переносить болезнь в...
-
что клещи часто бывают разносчиками инфекций, которые могут спровоцировать многие заболевания, самые опасные среди них – клещевой энцефалит и болезнь...
-
Дифтерия является опасным инфекционным заболеванием, которое становит угрозу для жизни. Наиболее восприимчивы к ней дети. Но за последнее время удвоил...
Рекомендованные клиники
-
Лікарня
-
Лікарня
-
Консультативно-діагностичний центр
-
Лікарня
-
Лікарня
ПУБЛИКАЦИИ КЛИНИК